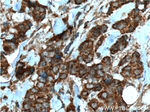
HCCS Antibody in Immunohistochemistry (Paraffin) (IHC (P))
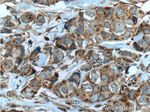
HCCS Antibody in Immunohistochemistry (Paraffin) (IHC (P))

Search
Proteintech
HCCS Polyclonal Antibody
{{$productOrderCtrl.translations['antibody.pdp.commerceCard.promotion.promotions']}}
{{$productOrderCtrl.translations['antibody.pdp.commerceCard.promotion.viewpromo']}}
{{$productOrderCtrl.translations['antibody.pdp.commerceCard.promotion.promocode']}}: {{promo.promoCode}} {{promo.promoTitle}} {{promo.promoDescription}}. {{$productOrderCtrl.translations['antibody.pdp.commerceCard.promotion.learnmore']}}
产品信息
15118-1-AP
种属反应
已发表种属
宿主/亚型
分类
类型
抗原
偶联物
形式
浓度
规格
纯化类型
保存液
内含物
保存条件
运输条件
产品详细信息
Immunogen sequence: MGLSPSAPA VAVQASNASA SPPSGCPMHE GKMKGCPVNT EPSGPTCEKK TYSVPAHQER AYEYVECPIR GTAAENKENL DPSNLMPPPN QTPAPDQPFA LSTVREESSI PRADSEKKWV YPSEQMFWNA MLKKGWKWKD EDISQKDMYN IIRIHNQNNE QAWKEILKWE ALHAAECPCG PSLIRFGGKA KEYSPRARIR SWMGYELPFD RHDWIINRCG TEVRYVIDYY DGGEVNKDYQ FTILDVRPAL DSLSAVWDRM KVAWWRWTS (1-268 aa encoded by BC001691 )
靶标信息
CCHL (cytochrome c-type heme lyase), also known as HCCS (holocytochrome c-type synthase), is a 268 amino acid mitochondrial inner membrane protein that belongs to the cytochrome c-type heme lyase family. Containing two HRM (heme regulatory motif) repeats, HCCS participates in the covalent linkage of a heme group to an apoprotein of cytochrome c. The gene encoding HCCS maps to the human X chromosome. Defects to this gene cause microphthalmia syndromic type 7 (MCOPS7), also known as MIDAS syndrome or microphthalmia with linear skin defects (MLS). MCOPS7 is an X-linked male-lethal disorder that results in eye deformation, unilateral or bilateral microphthalmia, linear skin defects in affected females, and in utero lethality for males.
仅用于科研。不用于诊断过程。未经明确授权不得转售。
生物信息学
蛋白别名: CCHL; cytochrome c heme-lyase; Cytochrome c-type heme lyase; Holocytochrome c-type synthase; holocytochrome-c synthetase; microphthalamia with linear skin defects; microphthalmia with linear skin defects; unnamed protein product
基因别名: CCHL; HCCS; LSDMCA1; MCOPS7; MLS
UniProt ID: (Human) P53701, (Mouse) P53702
Entrez Gene ID: (Human) 3052, (Mouse) 15159